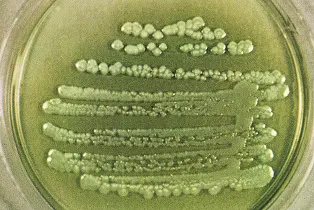

Mikrobiologi Pseudomonas aeruginosa
Kata Pseudomonas berarti “unit palsu” dari bahasa Yunani “Pseudo” yang berarti palsu dan “monas” yang berarti unit tunggal. Aeruginosa berasal dari bahasa Yunani “ae” yang berarti tua dan akhiran “ruginosa” berarti mengerut atau tidak rata. Suatu bakteri hijau kebiruan seringkali seperti tembagaberkarat jika dilihat pada kultur laboratorium dari Pseudomonas aeruginosa.
Klasifikasi
Pseudomonas aeruginosa memiliki klasifikasi sebagai berikut:
Divisi : Protophyta
Class : Schizomycetes
Ordo : Pseudomonadales
Subordo : Pseudomonadinae
Familia : Pseudomonadaceae
Genus : Pseudomonas
Spesies : Pseudomonas aeruginosa
Pseudomonas aeruginosa merupakan bakteri gram negatif, berbentuk batang lurus atau lengkung berukuran sekitar 0,6x2 µm, ditemukan tunggal, berpasangan, dan kadang-kadang membentuk rantai pendek, tidak memiliki spora, tidak mempunyai selubung (sheath), serta mempunyai flagel. Bakteri Pseudomonas aeruginosa memiliki dua atau tiga flagel sehingga selalu bergerak.
Pseudomonas aeruginosa merupakan bakteri aerob yang dapat tumbuh dengan mudah pada banyak jenis media pembiakan, karena memiliki kebutuhan nutrisi yang sangat sederhana. Koloni Pseudomonas aeruginosa mengeluarkan bau manis atau menyerupai anggur yang dihasilkan aminoasetafenon.
Pseudomonas aeruginosa menghasilkan satu atau lebih pigmen yang dihasilkan dari asam amino aromatik seperti tirosin dan fenilalanin. Beberapa pigmen tersebut antara lain: piosianin (pigmen warna biru), pioverdin (pigmen warna kuning), piorubin (pigmen warna merah), dan piomelanin (pigmen warna coklat).
Pseudomonas aeruginosa adalah satu-satunya spesies yang menghasilkan : Piosianin, suatu pigmen yang larut dalam khloroform.Strain lainnya menghasilkan pigmen fenazin. Pada perbenihan Pseudomonas pagar pembentukan pigmen akan bertambah.Fluoresen, suatu pigmen yang larut dalam air. Beberapa strain menghasilkan pigmen merah
Habitat Pseudomonas aeruginosa dapat ditemukan di tanah, air daerah lembab di kulit dan dapat membentuk kolonipada saluran pernafasan bagian atas.Pseudomonas aeruginosa merupakan bakteri penyebab penyakit infeksi nosokomial. Infeksi nosokomial adalah infeksi yang didapatkan setelah penderita dirawat di rumah sakit baik tumbuh pada saat dirawat di rumah sakit juga pada penderita yang pulang dari rumah sakit
Pseudomonas aeruginosa juga mampu tumbuh di lingkungan yang mengandung oli dan bahan bakar minyak lainnya. Sehingga, bakteri ini dapat digunakan untuk mendegradasi polutan hidrokarbon yang ada di lingkungan perairan maupun di tanah.
Bakteri ini terlihat sebagai bakteri tunggal, berpasangan, dan terkadang membentuk rantai yang pendek. Suhu optimum untuk pertumbuhan P. aeruginosa adalah 35oC sampai42o C. Pseudomonasaeruginosa mudah tumbuh pada berbagai media pembiakan karena kebutuhan nutrisinya sangat sederhana. Di laboratorium, medium paling sederhana untuk pertumbuhannya digunakan asetat (untuk karbon) dan ammonium sulfat (untuk nitrogen). Pseudomonas aeruginosa resisten terhadap beberapa antibiotik.
Pseudomonas aeruginosa lebih resisten terhadap disinfektan dari padabakteri lain. Bakteri ini menyenangi hidup dalam suasana lembab seperti pada peralatan pernafasan, air dingin, bedpan, lantai kamar mandi, tempat air dan lain-lainnya.
Kebanyakan antibiotika dan antimikroba tidak efektif terhadap bakteri ini. Pernah diisolasi dari gugusan NH4 dan dari sabun heksakhlorofen. Fenol dan beta-glutaraldehid biasanya merupakan disinfektan yang efektif. Air mendidih dapat membunuh bakteri ini.
Pemindahan gen antar strain Pseudomonas dapat terjadi melalui :
Konjugasi
transduksi
Resistensi terhadap karbenisilin secara genetik dapat dipindahkan melalui R faktor. Untuk membedakan strain satu sama lain ialah dengan jalan reaksi serologic, tipe faga dan tipe piosin (bacteriocin).
Pseudomonas aeruginosa dapat mengadakan infeksi pada jaringan atau bagian dari tubuh. Lesi lokal terjadi pada luka atau luka bakar, kornea, saluran kemih dan paru-paru. Selain daripada itu juga dapat menyebabkan endokarditis bakterialis dan gastroenteritis. Infeksi jaringan kornea dapat menyebabkan kebutaan. Dari infeksi lokal bakteriini dapat menyebar melalui darah, sehingga menyebabkan septikemia angka kematian dapat mencapai 80%.
Pada penyakit Pneumonia Pseudomonas biasanya terjadisianosis yang makin lama makinbertambah, biasanyadengan empiema. Dengansinar X dapatdilihatadanyainfiltrasi di dalamlobusbagianbawah yang bersifat nodular dan nekrosisdenganpembentukanabses. Pada penderitaleukemia mortalitas lebihtinggibilamenderitaleukopeni yang berat. Pada penderitadengan fibrosis kistik, organismeiniseringberkapsuluntukmencegahfagositosis.
Oleh: Desiana Ika Listiani
Klasifikasi
Pseudomonas aeruginosa memiliki klasifikasi sebagai berikut:
Divisi : Protophyta
Class : Schizomycetes
Ordo : Pseudomonadales
Subordo : Pseudomonadinae
Familia : Pseudomonadaceae
Genus : Pseudomonas
Spesies : Pseudomonas aeruginosa
![]() |
| Pewarnaan gram Pseudomonas aeruginosa |
Pseudomonas aeruginosa merupakan bakteri aerob yang dapat tumbuh dengan mudah pada banyak jenis media pembiakan, karena memiliki kebutuhan nutrisi yang sangat sederhana. Koloni Pseudomonas aeruginosa mengeluarkan bau manis atau menyerupai anggur yang dihasilkan aminoasetafenon.
Pseudomonas aeruginosa menghasilkan satu atau lebih pigmen yang dihasilkan dari asam amino aromatik seperti tirosin dan fenilalanin. Beberapa pigmen tersebut antara lain: piosianin (pigmen warna biru), pioverdin (pigmen warna kuning), piorubin (pigmen warna merah), dan piomelanin (pigmen warna coklat).
![]() |
| Koloni Pseudomonas aeruginosa |
Habitat Pseudomonas aeruginosa dapat ditemukan di tanah, air daerah lembab di kulit dan dapat membentuk kolonipada saluran pernafasan bagian atas.Pseudomonas aeruginosa merupakan bakteri penyebab penyakit infeksi nosokomial. Infeksi nosokomial adalah infeksi yang didapatkan setelah penderita dirawat di rumah sakit baik tumbuh pada saat dirawat di rumah sakit juga pada penderita yang pulang dari rumah sakit
Pseudomonas aeruginosa juga mampu tumbuh di lingkungan yang mengandung oli dan bahan bakar minyak lainnya. Sehingga, bakteri ini dapat digunakan untuk mendegradasi polutan hidrokarbon yang ada di lingkungan perairan maupun di tanah.
Bakteri ini terlihat sebagai bakteri tunggal, berpasangan, dan terkadang membentuk rantai yang pendek. Suhu optimum untuk pertumbuhan P. aeruginosa adalah 35oC sampai42o C. Pseudomonasaeruginosa mudah tumbuh pada berbagai media pembiakan karena kebutuhan nutrisinya sangat sederhana. Di laboratorium, medium paling sederhana untuk pertumbuhannya digunakan asetat (untuk karbon) dan ammonium sulfat (untuk nitrogen). Pseudomonas aeruginosa resisten terhadap beberapa antibiotik.
![]() |
| Terlihat pili Pseudomonas aeruginosa seperti jarum untuk proses konjugasi |
Pseudomonas aeruginosa lebih resisten terhadap disinfektan dari padabakteri lain. Bakteri ini menyenangi hidup dalam suasana lembab seperti pada peralatan pernafasan, air dingin, bedpan, lantai kamar mandi, tempat air dan lain-lainnya.
Kebanyakan antibiotika dan antimikroba tidak efektif terhadap bakteri ini. Pernah diisolasi dari gugusan NH4 dan dari sabun heksakhlorofen. Fenol dan beta-glutaraldehid biasanya merupakan disinfektan yang efektif. Air mendidih dapat membunuh bakteri ini.
Pemindahan gen antar strain Pseudomonas dapat terjadi melalui :
Konjugasi
transduksi
Resistensi terhadap karbenisilin secara genetik dapat dipindahkan melalui R faktor. Untuk membedakan strain satu sama lain ialah dengan jalan reaksi serologic, tipe faga dan tipe piosin (bacteriocin).
Pseudomonas aeruginosa dapat mengadakan infeksi pada jaringan atau bagian dari tubuh. Lesi lokal terjadi pada luka atau luka bakar, kornea, saluran kemih dan paru-paru. Selain daripada itu juga dapat menyebabkan endokarditis bakterialis dan gastroenteritis. Infeksi jaringan kornea dapat menyebabkan kebutaan. Dari infeksi lokal bakteriini dapat menyebar melalui darah, sehingga menyebabkan septikemia angka kematian dapat mencapai 80%.
Pada penyakit Pneumonia Pseudomonas biasanya terjadisianosis yang makin lama makinbertambah, biasanyadengan empiema. Dengansinar X dapatdilihatadanyainfiltrasi di dalamlobusbagianbawah yang bersifat nodular dan nekrosisdenganpembentukanabses. Pada penderitaleukemia mortalitas lebihtinggibilamenderitaleukopeni yang berat. Pada penderitadengan fibrosis kistik, organismeiniseringberkapsuluntukmencegahfagositosis.
Oleh: Desiana Ika Listiani

adm ,, bisa berikan saya info cara membedakan strai bakteri p. aeruginosa dengan p. fluorescens ?
BalasHapusperbedaannya terletak dia bisa menghasilkan flourescen dan tidak mbak.. piosianin dan pyoverdin
Hapusmungkin ini bisa dijadukan refernsi mbak....
https://www.ncbi.nlm.nih.gov/pmc/articles/PMC261925/
Nanti akan kami buatkan artikel khusus pembahasan ini perbedaannya apa... terimakasih mbak atas pertanyaannya...